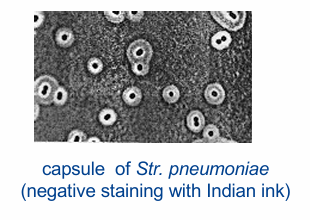
<p>= dikke wand polysacchariden rond bact (soms polypeptiden)</p><p>Capsule (‘kapsel’): duidelijk afgebakende structuur</p><ul><li><p>virulentiefactor: beschermt tegen fagocytose (suikers hetzelfde als lichaam)</p></li></ul><p>Slijmlaag (‘slijmlaag’): minder stevig verbonden met celwand</p><ul><li><p>hecht zich aan en beschermt cel tegen uitdroging</p></li></ul><p>Virulentiefactor (K-antigeen)</p>

1. Characteristics of prokaryotic cells
1/49
There's no tags or description
Looks like no tags are added yet.
Name | Mastery | Learn | Test | Matching | Spaced | Call with Kai |
|---|
No analytics yet
Send a link to your students to track their progress
50 Terms
Prokaryotes ↔ Eukaryotes
Prokaryoten: bact, archaea
geen celkern: DNA ligt los in cytoplasma in nucleoid
geen membraangebonden organellen: mitochondriën, GA, …
Eukaryoten: dieren, planten, schimmels, protisten
celkern: DNA zit in kernmembraan
membraangebonden organellen

Grootte
De meeste bacteriën: 0,5 tot 2,0 µm
Menselijke rode bloedcel: 7,5 µm

Vorm en indeling
Coccus: rond, groeien + naast elkaar in streep = streptococcus, trosje= staphylococcus
Bacillus: staafje, naast elkaar groeien = streptobacillus
bv: clostridium tetani (tetanus), lactobacillus bulgaricus (in yoghurt)
Spirochete: kurkentrekkervorm (bv borrelia burgdorferi→ lyme)
Vibrio: komma vorm, gebogen staafje (bv: v. cholerae→ cholera)

Overzicht structuur
Celmembraan, meestal omgeven door celwand
Intern cytoplasma met ribosomen, nucleair gebied, ...
Verscheidenheid aan externe structuren, zoals capsules, flagella en pili

Celwand
Bevindt zich buiten celmembraan
Functies: karakteristieke vorm cel en voorkomt dat cel barst (osmose)
Cholesterol zorgt CM niet openspringt →fluiditeit: bact heeft dit niet! gevoelig!
Penicilline of lysozym celwand aantasten
Bestanddelen celwand: peptidoglycaan, buitenmembraan, periplasmatische ruimte
Peptidoglycaan of mureïne
Bevat:
N-acetylglucosamine (NAG) en N-acetylmuraminezuur (NAM)
Cross linked door tetrapeptiden, met 3de AZ: lysine voor meeste grampos bact, diaminopimelinezuur (DAP) voor meeste gramneg bact
Disacharide-ruggengraat: identiek voor alle bact
Tetrapeptide: L-Alanine →D-glutamic acid →L-lysine/ DAP →D-Alanine

Gramneg versus grampos bact
Gramnegatief: meestal geen oligopeptidebrug, verbinding tussen DAP en D-Ala
Grampositief: oligopeptidebrug, 5 glycinemoleculen (S. aureus)

Grampos bact: celwand
Dikke laag peptidoglycaan: 60-90% celwand bestaat uit peptidoglycaan
Lipoteichoïnezuur en teichoïnezuur
Polymeren ribitolfosfaat of glycerolfosfaat
Bezitten neg elektrische ladingen: opp-antigeen, transport Ca2+ en Mg2+
Eiwitten: adhesiefactoren, productie capsule, penicillinebindend eiwit (PBP) in CM

Gramneg bact: celwand
Dunne laag peptidoglycaan: 10-20% celwand bestaat uit peptidoglycaan, verteerd peptidoglycaan levert sferoplasten op (2 membranen)
Periplasmatische ruimte= ruimte tussen cel en buitenmembraan, bevat peptidoglycaan, toxines en katabole enzymen
Eiwitten: adhesiefactoren, productie capsule, penicillinebindend eiwit (PBP) in CM

Gramneg bact: Lipopolysacchariden
of LPS of endotoxine (!)
buitenste domein: O of somatisch antigeen →samenstelling varieert stam tot stam, serologische classificatie
kernoligosacharide: 10-15 heptose- en octosesuikers, KDO = keto-deoxyoctulosonaat
lipide deel: lipide A →gefosforyleerde diglucosamine, meerdere VZ, zoals 3-hydroxy-myristinezuur (C14)
Groot risico: baxter= H2O + zouten + suiker
+ gram neg en pos →door hitte: bact dood (neg en pos dood)→ IV: dier gaat dood
probleem: bact afgedood →endotoxines zijn hitte stabiel! Shock!

LPS functie
Hecht zich aan specifieke weefsels
Antigene variatie
Beschermende permeabiliteitsbarrière:
LPS-moleculen en Ca2+
+ EDTA → barrièrefunctie verloren (rol in oordruppels)
bv:hond met oorontsteking: AB geven met hierin EDTA (ethyleen diamine tetra azijnzuur) →zorgt voor Ca wegnemen (binden aan COO- einden) →2 neg ladingen wel afstoten →antennes gaan uit elkaar wijken → AB gemakkelijker binnenkomen
Gramkleuring
Stap 1: kristalviolet 1min →paarskleuring: bevat pos geladen N →binden met iets neg
Stap 2: jood bij gedaan →kristalviolet binden →kristalvioletjood = sterkere kleur en groter molecule
Stap 3: Ontkleuren met ethanol en aceton
aceton: lipofiel middel, CM kapot maken
ethanol: denaturatie eiwitten (peptidoglycaanlaag →dichter samenkomen)
bij gram neg er door, maar niet bij gram pos →dikke laag peptidoglycaan (samengedrukt)
Stap 4: tegenkleuren met safranine →pos geladen
gram pos: alle plaatsen bezet →oorspronkelijke kleurstof paars
gram neg: alle kristalviolet weg →kleurt roos

Zuur vaste bact: celwand
= geen grampos en geen gramneg
Dunne laag peptidoglycaan
Arabinogalactanen: verbonden met peptidoglycaan→ verbonden met mycolzuren met hoog moleculair gewicht
Rijk aan lipiden (60% celwand) → LANGZAME GROEIERS !
Lipoarabinomannanen
Mycolzuren (C 100, lang)= β-hydroxy-α-alkylvetzuren

Ziehl-Neelsen of zuurvaste kleuring
Eerst kleuren met carbolfuchine
HCl (pH <1) toevoegen: ontkleurt en zuurvaste bact doet niks want gaat niet door celwand
Tegenkleuren: methyleenblauw, zuurvaste blijven eerste kleur behouden

Bacteriën zonder celwand
Mycoplasma
Chlamydia
Archaebacterien
Mycoplasma
Afwezigheid van celwand → pleomorf, vorm aannemen dat die wil
Stabiliteit van celmembraan door opname van sterolen (↔ andere bacteriën)
Zeer klein: 0,2 tot 0,8 µm

Chlamydia
Geen peptidoglycaan
Gramnegatieve bacterie
Obligaat intracellulair !
MOMP = belangrijk buitenmembraaneiwit

Archaebacteriën
Geen peptidoglycaan
Celmembraan: monolaag (40 C lang), ethergebonden (niet fosfolipiden!)
Nucleïnezuren: hittebestendige spiralen
Hittebestendige enzymen: meer hydrofobe AZ, extra bindingen tussen AZ
Archaebacteriën kunnen in extreem barre omstandigheden leven

Celmembraan
Vloeistofmozaïekmodel: fosfolipiden in vl toestand, eiwitten verspreid tussen lipiden→ mozaïekpatroon
Dubbele laag
Eiwitten

Celmembraan functies
Doorlaatbaarheidsbarrière: voorkomen grote stoffen naar buiten
Eiwitanker
Energiebesparing: elektronentransportketen →gradient, vorming ATP

Celmembraan: passief transport
Geen ATP nodig: diffusie doorheen membraan, eiwitkanaal, osmose via water

Celmembraan: actief transport
ATP nodig
Fosfaat zorgen dat het niet terug naar buiten kan gaan

Celmembraan: transport siderophores
Ijzer cofactor
ijzer 3+ complexeren (graakt niet op zijn eigen goed binnen) →via kanaal binnenkomen → uiteindelijk terecht in cel, ATP nodig →ijzer 3+ omgezet tot ijzer 2+ →in bep enzymes actief
Ijzer transport van buiten naar binnen

Interne structuren: cytoplasma en nucleoide
Cytoplasma: 80% water en 20% stoffen, zoals ionen en suikers
Nucleaire regio of nucleoïde
geen kernmembraan! en histon-eiwitten
bestaat voornamelijk uit DNA, maar ook uit wat RNA en eiwitten
meeste bact slechts 1 cirkelvormig chromosoom, vibrio cholerae: 2 chromosomen

Interne structuren: Ribosomen
20.000 ribosomen/bacterie, bestaat uit RNA en eiwitten
Functie: eiwitsynthese
Sedimentatiesnelheid in centrifuge
Svedberg (S)-eenheden: variëren naargelang moleculaire grootte en vorm
Eukaryoten: snelheid afh van gewicht →versch: niet enkel gewicht telt mee maar ook vorm →verandert: 80s en niet 100s
AB maken dat enkel werkt op ribosomen bact en niet op humane ribosomen →doelwit verschillend van mens – bact

Interne structuren: Inclusions
Korrels: = metachromatische korrels (versch kleurintensiteiten)
glycogeen (polymeer van glucose): energie
polyfosfaat (fosfaatpolymeer)
Vesikels: door membranen omgeven structuren
met gas gevulde vacuolen → fotosynthetische bact en cyanobact

Interne structuren: cytoskelet
Bepaalt vorm van de bacterie
Cytoskelet → bacillus
Geen cytoskelet → coccus

Endosporen
Meest resistente van alle levensvormen (≠ schimmelsporen!)
Om te ontsnappen aan ongunstige omgevingsomstandigheden: uitputting voedingsstoffen, hoge temp, ...
Geslachten (Gram-pos): voornamelijk Bacillus en Clostridium

Endosporen: kieming
= terugkeer naar vegetatieve toestand vanuit spore
Stel slechte omstandigheden: sommige bact omvormen tot endosporen = sporulatie
septum gevormd en kopie gemaakt van chromosoom
voorspoor ontstaat: stadium voor dat je endospore krijgt
2de membraan gevormd rond bact chromosoom
vorming cortex: peptidoglycaanlaag
vorming proteinen rond cortex: heel stabiel, dikke laag
dipicolinezuur →watergehalte doen dalen
rest bact kapot →endospore volledig loskomen (jaren aanwezig blijven)

Dipicolinezuur
Capteert Ca2+
Aanwezig in endospore, maar NIET in vegetatieve bacteriën
Draagt bij aan hittebestendigheid vanwege het zeer lage watergehalte

Externe structuren
Immuunsysteem kan deze structuren herkennen
Flagella, Axial filaments, Pili, Glycocalyx

Flagella
Bestaat uit filament + haak + basaal lichaam: filament → eiwitten (flagelline) in helix
Lengte: 15-20 µm en 20 nm dik
LM: alleen zichtbaar na kleuring, EM: zichtbaar
Haakflagellum: meestal 90° → “propeller”, energie: protonpomp voor ATP
Grampos: 2 ringen ↔ Gramneg: 4 ringen
Virulentiefactor (H-antigeen)

Flagella soorten
Monotrichous: 1
Amphitrichous: 2, elk aan 1 zijde
Lophotrichous: op 1 plek meerdere flagellen
Peritrichous: 30-40 flagellen

Flagella beweging
Aantrekkende of afstotende stof→ receptoren of transducers→ protonmotieve kracht (energie)→ pos of neg chemotaxis
Bact: glucose naar toe gaan, zwak zuur van weg gaan
Propeller: met klok draaien of tegen klok draaien→ wijzerzin: draaien, tegenwijzerzin: naar voor gaan
Bact snel? Relatief gezien snel (3x sneller dan jachtluipaard proportioneel gezien, niet km/h gezien)

Axial filaments
Spirochetes: Treponema pallidum, Borrelia burgdorferi

Pili en fimbriae
Samengesteld uit subeenheden eiwit piline
Conjugatiepili of F-pili: overdracht DNA tussen 2 bact (plasmiden), resistentie
Hechtingspili of fimbriae: helpen bact zich aan opp hechten
virulentiefactor: Neisseria gonorrhoeae → hechting aan epitheelcellen
Virulentiefactor (F-Antigen)

Glycocalyx
= dikke wand polysacchariden rond bact (soms polypeptiden)
Capsule (‘kapsel’): duidelijk afgebakende structuur
virulentiefactor: beschermt tegen fagocytose (suikers hetzelfde als lichaam)
Slijmlaag (‘slijmlaag’): minder stevig verbonden met celwand
hecht zich aan en beschermt cel tegen uitdroging
Virulentiefactor (K-antigeen)
Biofilms
=Aan opp gehechte gemeenschappen van bacteriën, omhuld door zelf geproduceerde extracellulaire matrix, die fenotypes aannemen die verschillen van die van planktonische cellen
Planktonische bact: zwemt rond alleen→ genotype hetzelfde, maar fenotype verschilt
fenotype: minder zuurstof, voedingsstoffen krijgen→ metabool minder actief
Vorming biofilm: bact en schimmels hechten aan biotische en abiotische opp

Stadia biofilmvorming

Quorum sensing
=Hoe bacteriën communiceren, afgifte specifieke signaalmoleculen = auto-inductoren
Lux-systeem in Vibrio fischeri
Synergie: licht-aanmakende bact en inktvis
Bact: groeien op inktvis, hebben opp met eten dat voorbijkomt
Inktvis: licht zorgt dat roofdier moeilijk weet waar inktvis zit →bescherming

Quorum sensing vb
Vibrio →2 bact die genetisch gezien hetzelfde zijn
Bovenaan planktonisch
Luciferase: luxI →lactone: signaalmoleculen →diffundeert naar buiten
Niet binden met luxR (regulator): binden met promoter
Lux niet afgelezen = geen licht
Onderste planktonische bact die in biofilm zit
LuxI maakt lactone →deel naar buiten, maar door veel bact ook naar binnen komen
Binden met luxR (regulator) →binden promoter →lux operon aflezen →luciferase = licht
In community met zoveel bact: samen iets doen →licht maken

Biofilms: toepassingen

Biofilms: infecties bij mensen

Biofilms – overleven als gemeenschap
1) Verminderde penetratie van antimicrobiële middelen
2) Lagere zuurstofniveaus in biofilm
3) Weerstand tegen afweermechanismen van de gastheer
4) Persisters
1) Verminderde penetratie antimicrobiële middelen
Bact in biofilm moeilijk zuurstof, voeding en AB en ontsmettingsmiddelen krijgen
MIC: min inhiberende concentratie , laagste concentratie die bact groei remt
Voldoende om kiem inhiberen, MAAR beneden in biofilm lager dan MIC
Sub-MIC in biofilm verhoogt risico op resistentie-inductie
Pos geladen AB kunnen zich binden aan alginaat
Levende bact met ontsmettingsgroep →heel veel rood, dikke biofilm: groen

2) Lagere zuurstofniveaus in biofilm
Zuurstofgradiënt in biofilm afhankelijk van stroomsnelheid
GFP-gemarkeerde Pseudomonas putida, SYTO-gemarkeerde bacteriën
Centrale celcluster biofilm
In midden biofilm: bijna 0% zuurstof
Bact krijgen geen zuurstof en geen voedingsstoffen →slapen
AB: celwand synthese, eiwit synthese →inwerken op groeiende levende actieve bact

3) Weerstand tegen afweermechanismen van de gastheer
Luchtwegen met gezonde epitheelcellen (lichtblauw) en alveolaire macrofaag (geel)
Rood bolletje: planktonische cel →opgegeten door macrofaag
Blauw: biofilmcellen met matrix er rond
Macrofaag voelt dat er bact zitten dus gaat radicalen en enzymes aanmaken →maakt zich klaar om bact dood te maken MAAR kan er niet door
Radicalen vrijkomen en reageren met eigen cellen = gefrustreerde fagocytose

4) Persisters
AB toevoegen: bact afdoden →verwachten helemaal op x as MAAR is niet
Plateau fase:
Waarom blijven? →resistent: isoleren →terug opgroeien zonder AB →AB hierna toevoegen: bact niet afgedood →verhogen zelfs
Persistes: resistent maar slapen beetje: isoleren →terug opgroeien zonder AB →AB hierna toevoegen: bact afgedood voor deel

Huidige strategieën tegen biofilms
Preventie: regelmatige reiniging en desinfectie, volledige preventie vrijwel onmogelijk
Behandeling en verwijdering van biofilms: Sterilex®
Verwijdering geïnfecteerd apparaat: laatste optie
Cystische fibrose
Pseudomonas aeruginosa, Burkholderia cepacia
Kanaal Cl ionen in lumen brengen, als kanaal defect→ dikke mucus
Taai slijm: ideale omgeving bact om zich te verstoppen en moeilijk te behandelen
Heel snel en gemakkelijk luchtweginfecties
